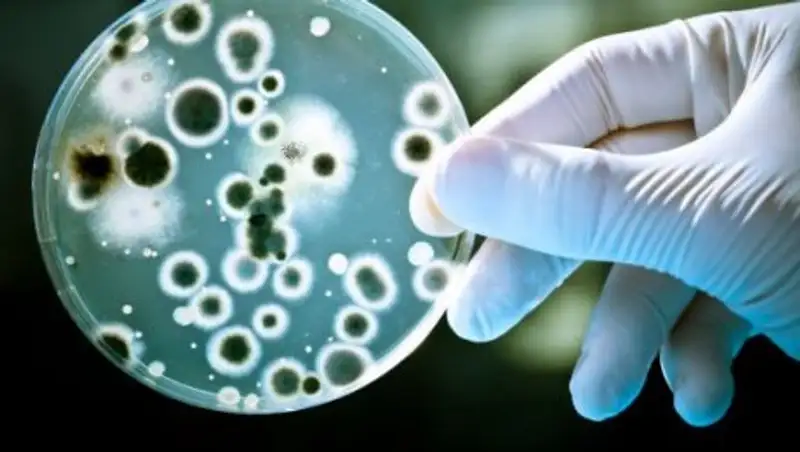

В завезенных в Казахстан продуктах нашли запрещенные и вредные вещества
mgov.kz
mgov.kz
По результатам мониторинговых исследований пищевой продукции Министерством сельского хозяйства Республики Казахстан были введены временные ограничения в отношении продукции произведенной предприятием ЗАО "Ставропольский бройлер", Ставропольский край — крыло цыпленка–бройлера "Благояр" — превышение нормативного значения КМАФАнМ (количество мезофильных аэробных и факультативно анаэробных микроорганизмов). Об этом сообщает Zakon.kz со ссылкой на МСХ РК.
Также в связи с первичным выявлением введен режим усиленного лабораторного контроля с отбором проб каждой партии товаров продукции ООО "СПК "Курников", Саратовская область, РФ — куриный фарш превышение нормативного значения КМАФАнМ.
Ранее министерством ввиду несоответствия ветеринарно-санитарным требованиям были введены временные ограничения на ввоз продукции ООО "ФинИнвест", Челябинская область, ЗАО "Микояновский мясокомбинат", г.Москва, ЗАО "Приосколье", Белгородская область, ООО "Чебаркульская птица" Челябинская область, ООО "Брянский бройлер" Брянская область, ООО "Магнитогорский птицеводческий комплекс", ОАО "Токаревская птицефабрика", АО "Алтайский бройлер", СПСК "Расковский молзавод".
Увеличение КМАФАнМ свидетельствует о размножении микроорганизмов, в числе которых могут оказаться патогены и микроорганизмы, вызывающие порчу продукта.












